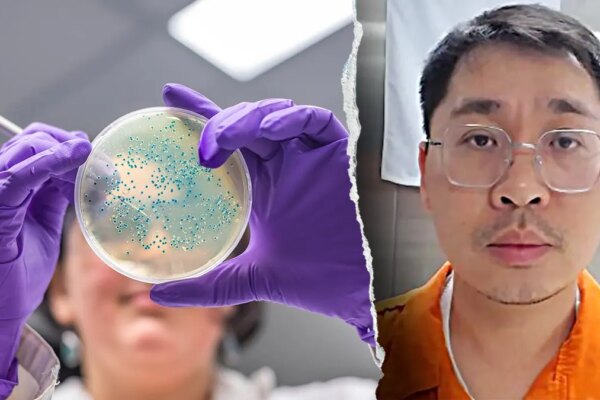
Split image of E. coli bacteria sample in a lab and Chinese researcher Youhuang Xiang

Indiana University researcher sentenced for smuggling E. coli into US
NEWYou can now listen to Fox News articles! A Chinese researcher was sentenced to more than four months in prison after pleading guilty to smuggling Escherichia coli (E. coli) into the United States, federal prosecutors announced Tuesday. Youhuang Xiang, 32, a former Indiana University postdoctoral researcher and Chinese national, admitted to concealing E. coli DNA…
